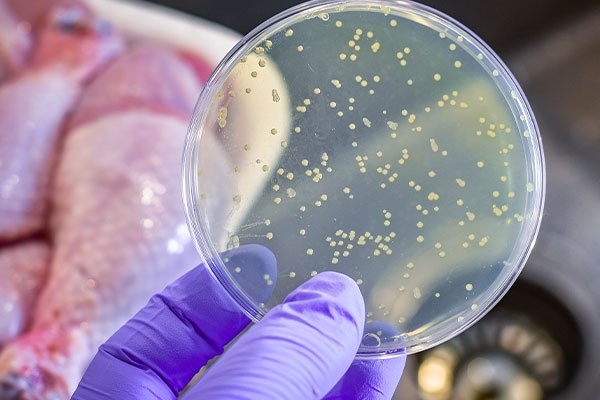
Salmonella anh 2

Sau bữa trưa gồm cơm, gà kho gừng, canh bắp cải nấu thịt, dưa leo xào và mận, nhiều học sinh tại trường Tiểu học Bình Quới Tây bắt đầu xuất hiện các triệu chứng như sốt, đau bụng và được đưa đến phòng y tế. Số ca có biểu hiện bất thường sau đó tăng nhanh, đến ngày 13/4 ghi nhận gần 200 học sinh nghi ngộ độc thực phẩm.
Kết quả xét nghiệm sau đó xác định 17 mẫu phân dương tính với vi khuẩn Salmonella tại Bệnh viện Nhân dân Gia Định.Sau đó, đơn vị Nghiên cứu Lâm sàng Đại học Oxford (OUCRU) đã định danh chính xác tác nhân là Salmonella enteritidis bằng kỹ thuật PCR.
Đáng chú ý, đây không phải lần đầu tác nhân này gây ra các vụ ngộ độc tập thể quy mô lớn tại TP.HCM. Trước đó, Salmonella từng được xác định là "thủ phạm" trong loạt vụ ngộ độc bánh mì. Diễn biến tại trường Bình Quới Tây một lần nữa cho thấy sự hiện diện phổ biến và mức độ khó lường của loại vi khuẩn này trong chuỗi cung ứng thực phẩm đô thị.
 |
| Bệnh nhi nghi bị ngộ độc thực phẩm được điều trị tại Bệnh viện Nhi đồng 2. Ảnh: BVCC. |
Tác nhân của hàng loạt ca ngộ độc
Vào mùa thu năm 1994, cơ quan y tế bang Minnesota ghi nhận hàng loạt ca nhiễm vi khuẩn Salmonella enteritidis. Qua điều tra, nguồn lây được xác định đến từ kem sản xuất hàng loạt, vốn bị nhiễm khuẩn trong quá trình chế biến.
Cụ thể, nhà phân phối Schwan’s đã sử dụng các xe bồn từng chở trứng chưa tiệt trùng để vận chuyển hỗn hợp làm kem. Vi khuẩn Salmonella còn sót lại đã xâm nhập vào nguyên liệu, sau đó lan rộng qua các sản phẩm kem vani đóng hộp. Ước tính khoảng 224.000 người tại 41 bang bị ảnh hưởng. Trong đó, gần 600 ca đã được báo cáo chính thức cho Trung tâm Kiểm soát và Phòng ngừa Dịch bệnh (CDC) Mỹ.
Vào năm 1985, một vụ bùng phát nhiễm khuẩn Salmonella liên quan đến sữa đã gây chấn động tại Mỹ, xuất phát từ hệ thống trang trại sữa Hillfarm do chuỗi bán lẻ Jewel vận hành. Cơ quan y tế bang Illinois ghi nhận tới 5.295 trường hợp nhiễm khuẩn tại nhiều bang, bao gồm Indiana, Michigan, Iowa, Wisconsin và Illinois, trong đó có 9 ca tử vong. Sự việc nhanh chóng được xác định có liên quan đến các sản phẩm sữa phân phối rộng rãi trong hệ thống cửa hàng của Jewel.
|
| Vi khuẩn Salmonella là tác nhân đứng sau nhiều vụ ngộ độc. Ảnh: Shutterstock. |
Cuộc điều tra cho thấy vi khuẩn Salmonella xuất hiện trong một lô sữa Bluebrook 2% sản xuất cuối tháng 3 tại nhà máy Hillfarm ở Melrose Park. Dù đã tiến hành thu hồi, Jewel vẫn tiếp tục bán sữa nhiễm khuẩn trong khoảng một tuần sau khi phát hiện vấn đề. Nhà máy sau đó buộc phải đóng cửa vào ngày 9/4.
Năm 2011, một vụ bùng phát nhiễm khuẩn Salmonella liên quan đến thịt gà xay đã làm dấy lên lo ngại trên toàn nước Mỹ. Tâm điểm của sự việc là Cargill Meat Solutions - doanh nghiệp chế biến và phân phối thịt gà tây dưới nhiều thương hiệu, đồng thời cung cấp sản phẩm cho các chuỗi siêu thị lớn.
Do phần lớn nguồn cung thịt gà tây xay của công ty xuất phát từ một nhà máy tại Springdale (bang Arkansas), chỉ cần một điểm nhiễm khuẩn cũng có thể ảnh hưởng đến quy mô toàn quốc. Tháng 8/2011, công ty buộc phải thu hồi sản phẩm và tạm ngừng sản xuất sau khi cơ quan y tế truy vết được chủng Salmonella Heidelberg tại nhà máy này.
Các sản phẩm chế biến trong khoảng từ ngày 20/2 đến 2/8 được xác định không an toàn. Đến tháng 11 cùng năm, khi CDC tuyên bố kiểm soát được dịch, đã có 136 người tại 34 bang mắc bệnh sau khi tiêu thụ thịt gà tây nhiễm khuẩn.
Hàng triệu ca ngộ độc mỗi năm
Salmonella là một chi vi khuẩn hình que gram âm, thuộc họ Enterobacteriaceae, phân bố rộng rãi trong tự nhiên. Phần lớn các serotype (huyết thanh) của Salmonella có thể tồn tại trên nhiều vật chủ khác nhau, từ động vật đến con người.
Trong số các serotype, Salmonella enterica serotype Enteritidis và Salmonella enterica serotype Typhimurium được xem là hai tác nhân quan trọng nhất, thường lây truyền từ động vật sang người và gây bệnh phổ biến trên toàn thế giới.
 |
| Tổn thương trên da do vi khuẩn Salmonella. Ảnh: CDC Mỹ. |
Theo Tổ chức Y tế Thế giới (WHO), mỗi năm thế giới ghi nhận gần 94 triệu ca nhiễm Salmonella, khiến hơn 155.000 người không qua khỏi. Đáng chú ý, trẻ em dưới 5 tuổi chiếm tới khoảng 40% tổng số ca mắc, cho thấy mức độ ảnh hưởng không nhỏ của loại vi khuẩn này đối với sức khỏe cộng đồng toàn cầu.
Điểm đáng lo ngại của Salmonella nằm ở khả năng thích nghi môi trường rất cao. Vi khuẩn có thể phát triển trong dải nhiệt độ rộng, từ khoảng 5°C đến hơn 46°C, thậm chí tồn tại trong nhiều tháng ở điều kiện đông lạnh. Chính vì vậy, chúng dễ dàng “ẩn mình” trong thực phẩm chế biến sẵn hoặc bảo quản lạnh.
Ở người, nhiễm khuẩn Salmonella chủ yếu xảy ra khi ăn phải thực phẩm có nguồn gốc động vật bị nhiễm khuẩn như trứng, thịt, gia cầm và sữa. Tuy nhiên, rau xanh bị nhiễm phân chuồng hoặc nguồn nước bẩn cũng có thể trở thành nguồn lây. Ngoài ra, vi khuẩn còn có thể lây truyền từ người sang người qua đường phân - miệng nếu không đảm bảo vệ sinh.
5 nguyên tắc an toàn
Bệnh nhiễm khuẩn Salmonella do vi khuẩn Salmonella gây ra. Các biểu hiện thường xuất hiện sau 6-72 giờ kể từ khi ăn phải thực phẩm nhiễm khuẩn, phổ biến nhất trong khoảng 12-36 giờ, và kéo dài từ 2 đến 7 ngày. Trong đa số trường hợp, bệnh diễn tiến tương đối nhẹ và người bệnh có thể tự hồi phục mà không cần điều trị đặc hiệu.
Tuy nhiên, theo Cục Quản lý Thực phẩm và Dược phẩm Mỹ (FDA), ở những trường hợp nặng hơn, người bệnh có thể gặp các biểu hiện nghiêm trọng như sốt cao, đau nhức toàn thân, đau đầu, mệt mỏi, phát ban, thậm chí có máu trong nước tiểu hoặc phân, và trong một số trường hợp có thể đe dọa tính mạng.
 |
| Nhóm có nguy cơ cao khi nhiễm Salmonella thường bao gồm trẻ nhỏ, người cao tuổi. Ảnh: Adobe Stock. |
Những nhóm có nguy cơ cao khi nhiễm Salmonella thường bao gồm trẻ nhỏ, đặc biệt là dưới 5 tuổi, người cao tuổi và những người có hệ miễn dịch suy yếu như bệnh nhân đang điều trị ung thư, mắc bệnh mạn tính hoặc sử dụng thuốc ức chế miễn dịch.
Bên cạnh đó, những người thường xuyên tiếp xúc hoặc làm việc với động vật cũng thuộc nhóm có nguy cơ cao. Trong quá trình chăm sóc, chăn nuôi hoặc giết mổ, vi khuẩn có thể bám vào tay, dụng cụ hoặc bề mặt tiếp xúc, từ đó lây sang thực phẩm nếu không đảm bảo vệ sinh.
Để phòng ngừa nguy cơ nhiễm Salmonella, WHO khuyến cáo tuân thủ “5 chìa khóa an toàn thực phẩm”, bao gồm giữ vệ sinh sạch sẽ, tách riêng thực phẩm sống và chín, nấu chín kỹ, bảo quản thực phẩm ở nhiệt độ an toàn và sử dụng nguồn nước cùng nguyên liệu sạch.
Thế nào là chế độ ăn kiêng tốt nhất? Làm thế nào để ngừng lo lắng về cân nặng và tập trung vào việc sống lành mạnh? Để giải quyết mối quan tâm về vấn đề này, mục Sức khỏe của Zing giới thiệu bạn cuốn sách Chỉ dẫn để sống khỏe toàn diện của tác giả Shaun Francis.


